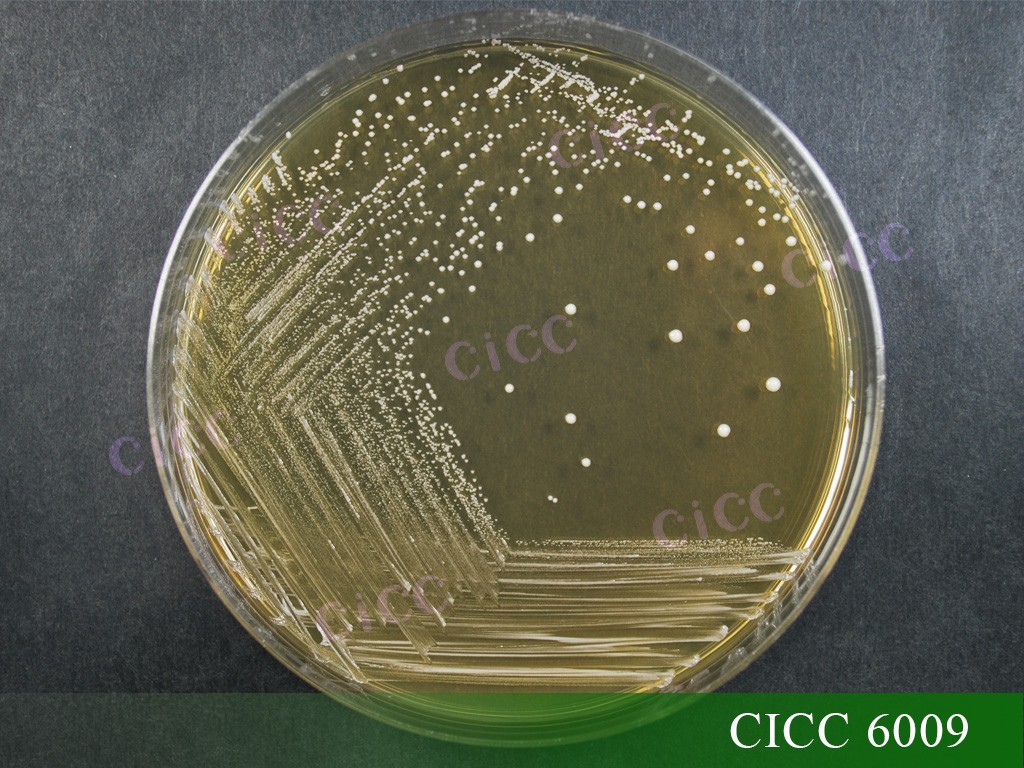
6009 菌落.jpg

植物乳植桿菌
植物乳植桿菌不僅在自然界中廣泛分布,在人類和其他哺乳動物的口腔和消化器官中也有所發現[1],是一種公認的益生菌,在各類食品中有長期的安全使用歷史,被收錄于歐洲食品安全局(EFSA)資格認定(Qualified Presumption of Safety, QPS)名單、美國食品藥品監督管理局(FDA)公認安全物質(Generally recognized as safe, GRAS)名單[2],是我國《可用于食品菌種名單》和《可用于嬰幼兒食品的菌種名單》收錄菌種[3]。
本文將詳細介紹植物乳植桿菌的發展歷史、研究進展、應用情況、國內外保藏情況以及特征特性,幫助大家更全面的了解植物乳植桿菌。
發展歷史
1919年:由Orla-Jensen首次提出植物乳植桿菌,并將其命名為Streptobacterium plantarum,但沒有將該名稱作為一個新的菌種名稱有效發布[4]。
1923年:《伯杰鑒定細菌學手冊》第一版將其重新命名為植物乳桿菌(Lactobacillus plantarum)[5]。
1980年:《國際系統與進化微生物學雜志》(International Journal Of Systematic And Evolutionary Microbiology,IJSEM),按照國際原核生物系統學委員會(International Committee on Systematic Prokaryotes, ICSP)規定,在《細菌名稱確認名錄》(Approved Lists of Bacterial Names)中正式提出并有效公布了Lactobacillus plantarum這一名稱[6]。
2020年:來自全球7個國家、12家權威機構的15位科學家利用大量已公布的全基因組數據,通過生物信息學分析完成了乳桿菌屬的重要分類學變遷研究,將乳桿菌屬重新劃分為25個屬,其中,Lactobacillus plantarum的分類學位置變遷為Lactiplantibacillus plantarum[7]。
2022年:國家衛健委發布關于《可用于食品的菌種名單》和《可用于嬰幼兒食品的菌種名單》更新公告,將植物乳桿菌(Lactobacillus plantarum)更名為植物乳植桿菌(Lactiplantibacillus plantarum)[8]。
研究進展
植物乳植桿菌作為益生菌的一種,它不僅具有較強的耐酸、耐膽鹽能力,同時還具有提高機體免疫,改善腸道菌群結構及功能、維持腸道菌群平衡、降低膽固醇等益生特性[9]。
免疫調節作用
乳酸菌在人體腸道內生長繁殖的過程能夠有效地刺激機體的免疫系統,激發免疫細胞的活性從而大量繁殖,保護人體免受病毒侵害。
植物乳植桿菌L-137(HK-LP)能夠在體內和體外對白細胞介素起到強誘導作用,其不僅可減輕食源性過敏小鼠的癥狀,而且還能抑制小鼠體內癌細胞的增長[10];Yosuke等人[11]研究發現,口服植物乳植桿菌AYA可顯著提高小鼠腸道和肺部免疫球蛋白A(Immunoglobulin A,IgA)的含量,并提高流感病毒感染小鼠的存活率;此外,成年人若每日攝取HK-LP可增強其獲得性免疫,特別是與輔助性T細胞1(helper T cell 1,Th1)相關的免疫功能[12]。
維持腸道菌群平衡
植物乳植桿菌相較于其他乳桿菌而言有著良好的耐酸、耐膽鹽與耐滲透壓能力,保證了其在腸道內的存活[13],而其優異的細胞粘附能力與生物膜形成能力使得其易在人體腸道內定殖,植物乳植桿菌在腸道內定植后可產生細菌素、有機酸和二乙酰等抗菌物質,從而抑制有害菌的生長,維持腸道菌群平衡,改善便秘、腹瀉等腸道疾病。
Xu等[14]研究發現含有植物乳植桿菌P-8的復合益生菌Probio-Fit可以顯著改善犬的腸道菌群,有效緩解犬類腹瀉的癥狀,通過增加免疫因子和降低促炎細胞因子的水平來增強其腸道免疫屏障功能。動物實驗表明,植物乳植桿菌BF-15能有效地平衡小鼠腸道微生物群失調,同時有效地減輕環磷酰胺誘導的免疫抑制[15]。
預防慢性代謝疾病
植物乳植桿菌可有效調節血糖、血脂、血壓平衡,具有改善代謝紊亂的作用[16,17],還可抑制葡萄糖代謝相關酶(α-葡萄糖苷酶或α-淀粉酶)的影響,從而緩解與糖尿病相關的病理指標。
LI等[16]通過建立高血脂大鼠模型,發現植物乳植桿菌NCU116能夠顯著增加血清中高密度脂蛋白膽固醇(HDL-C)水平,降低血清中總膽固醇(TC)、總甘油三酯(TG)和低密度脂蛋白膽固醇(LDL-C)的含量,改善血脂異常。Huang等[18]研究發現,補充植物乳植桿菌K68,能夠顯著降低大鼠體內促炎細胞因子IL-1β、IL-6和TNF-α的含量,有助于緩解大鼠的高血糖、高胰島素和高血脂癥。Lin等研究表明,長期灌胃植物乳植桿菌SR37-3和植物乳植桿菌SR61-2發酵乳,能顯著降低高血壓模型大鼠的血壓,并減輕腎臟損傷程度[19]。Chen[20]的研究發現植物乳植桿菌P-8可以顯著增強二甲雙胍的降血糖作用,可用于Ⅱ型糖尿病的輔助治療。
應用情況
植物乳植桿菌因其特殊的益生作用被廣泛應用于食品、動物飼料以及醫療保健等領域,具有巨大的市場需求和發展潛力。
在食品領域,植物乳植桿菌作為食品發酵劑和益生菌食品的原料,廣泛應用于酸奶、干酪、發酵香腸、面包、泡菜和發酵飲料中,通過將食品中的糖轉變為乳酸,改善產品的營養狀況和風味;植物乳植桿菌同時可以通過產生抗菌肽、胞外多糖等代謝產物,延長產品的保質期。
在飼料領域,植物乳植桿菌作為一種新型微生態制劑,常以補充劑的形式加入飼料中,在畜牧業生產中得到廣泛應用。植物乳植桿菌對家禽的生長及健康狀況具有一定程度的改善作用,同時有提高營養物質吸收、刺激宿主免疫系統、降低膽固醇、抗氧化、調節腸道微生物組成等功能[21,22],還可以通過提升飼料的轉化率,提高經濟效益。
在醫療保健領域,植物乳植桿菌常以活菌制劑的形式用于疾病的輔助治療。如Chingwaru等[23]研究表明,從食品中分離出的植物乳植桿菌CLP1、CLP2 和CLP3,均可顯著抑制E. coli感染引起兒童腸胃炎,具有治療兒童腹瀉的潛質。Liu等[24]通過臨床實驗,發現口服植物乳植桿菌CCFM8610產品可緩解腸易激綜合征(IBS)患者的臨床癥狀。
國內外保藏情況
植物乳植桿菌在多個國際微生物菌種保藏中心均有保藏,其中CICC保藏有模式菌株CICC 6240,與多家國際知名菌種保藏中心模式菌株等同編號,如:ATCC 14917、DSM 20174、JCM 1149,可用于分類研究“種”的參考模型。
此外,CICC還保藏有不同來源及用途的植物乳植桿菌300余株,如:
CICC 6009,可作為陽性對照菌株,適用于GB 4789.35-2023《食品安全國家標準 食品微生物學檢驗 乳酸菌檢驗》。
CICC 25024,可作為標準菌株用于GB 4789.28-2024《食品微生物學檢驗 培養基和試劑的質量要求》中MRS瓊脂培養基的質量檢測。
CICC 25215,具有較好的抑菌性能,可有效抑制大腸桿菌、單增李斯特氏菌、金黃色葡萄球菌及腸沙門氏菌等食源性致病菌。
特征特性
革蘭氏陽性菌,菌體桿狀(0.9-1.2 μm×3.0-8.0 μm),單個、成對或成鏈排列。

菌落為圓形,凸起,邊緣光滑,細密,乳白色。
兼性厭氧細菌,最適生長溫度30-37℃,最適pH6.5左右,全基因組長度介于2.91~3.70 Mb,GC含量為44.2%~45.1%[25]。
常常發酵α-甲基-D-葡糖甙和松三糖,有些菌株發酵α-甲基-D-甘露糖甙;有些發酵阿拉伯糖、木糖,通常不還原硝酸鹽。
中國工業微生物菌種保藏管理中心(CICC)是國家級工業微生物菌種保藏機構,保藏各類微生物資源14000余株,570余個屬,1490余個種,菌株性能優良,廣泛應用于食品、發酵、生產、科研等多個領域,為我國工業領域的質量安全、技術創新和產業升級保駕護航。
參考文獻
[1] Ryu E H, Yang E J, Woo E R, et al. Purification and characterization of antifungal compounds from Lactobacillus plantarum HD1 isolated from kimchi[J]. Food Microbiol, 2014, 41(7): 19-26.
[2] Ricci A, Allende A, Bolton D, et al. Update of the list of QPS‐recommended biological agents intentionally added to food or feed as notified to EFSA 5: suitability of taxonomic units notified to EFSA until September 2016[J]. EFSA Journal, 2017, 15(3): 24-26.
[3] 食品安全標準與監測評估司. 可用于食品的菌種名單和可用于嬰幼兒食品的菌種名單[Z]. 國家衛生健康委, 2022.
[4] Orla-Jensen S. The lactic acid bacteria. H?st, Copenhagen, 1919.
[5] Bergey DH, Harrison FC, Breed RS, Hammer BW, Huntoon FM. Bergey's Manual of Determinative Bacteriology, 1st ed. The Williams & Wilkins Co, Baltimore, 1923.
[6] Skerman VBD, McGowan V, Sneath PHA. Approved lists of bacterial names. Int J Syst Bacteriol 1980; 30:225-420.
[7] Zheng J, Wittouck S, Salvetti E, et al. A taxonomic note on the genus Lactobacillus: Description of 23 novel genera, emended description of the genus Lactobacillus Beijerinck 1901, and union of Lactobacillaceae and Leuconostocaceae[J]. International journal of systematic and evolutionary microbiology, 2020, 70(4): 2782-2858.
[8] 食品安全標準與監測評估司. 解讀關于《可用于食品的菌種名單》和《可用于嬰幼兒食品的菌種名單》更新的公告, 2022.
[9] 肖仔君,鐘瑞敏,陳惠音,等.植物乳桿菌的生理功能與應用[J].中國食品添加劑,2005(2):87-89.
[10] Murosaki S, Y Yamamoto, K Ito, et al. Heat-killed Lactiplantibacillus plantarum L-137 suppresses naturally fed antigen-specific IgE production by stimulation of IL-12 production in mice [J]. Journal of Allergy & Clinical Immunology, 1998, 102(1): 57-64.
[11] Kikuchi Y, Kunitoh-Asari A, Hayakawa K, et al. Oral administration of Lactobacillus plantarum strain AYA enhances IgA secretion and provides survival protection against influenza virus infection in mice[J]. PloS one, 2014, 9(1): e86416.
[12] 王水泉. 益生植物乳植桿菌P8在豆乳及牛乳中發酵特性的研究 [D]. 內蒙古農業大學, 2011.
[13] Haghshenas B,Nami Y,Haghshenas M,et al. Bioactivity characterization of Lactobacillus strains isolated from dairy products[J]. MicrobiologyOpen,2015,4(5): 803-813.
[14] Xu HY,et al.Oral administration of compound probiotics improved canine feed intake,weight gain, immunity and intestinal microbiota[J].Frontiers in Immunology,2019,10:666.
[15] Na Zhang, Chen Li, Zhihua Niu et al. Colonization and irnmunoregulation of Lactobacillus plantarum BF 15, a novel infants[J]. Food&Function, 2020, 11(4):probiotic strain from the feces of breast-fed 3156-3166.
[16] LI C, NIE S P, ZHU K X, et al. Lactobacillus plantarum NCU116 improves liver function, oxidative stress and lipid metabolism in rats with high fat diet induced non-alcoholic fatty liver disease[J]. Food & Function, 2014, 5(12):3216-3223.
[17] LI X, WANG N, YIN B, et al. Effects of Lactobacillus plantarum CCFM0236 on hyperglycaemia and insulin resistance in high-fat and streptozotocin-induced type 2 diabetic mice[J]. Journal of Applied Microbiology. 2016, 121(6):1727-1736.
[18] HUANG H Y, KORIVI M, TSAI C H, et al. Supplementation of Lactobacillus plantarum K68 and fruit-vegetable ferment along with high fat-fructose diet attenuates metabolic syndrome in rats with insulin resistance[J]. Evidence-Based Complementray and Alternative Medicine, 2013(1):943020.
[19] Yuan L, Li Y, Chen M, et al. Antihypertensive activity of milk fermented by Lactiplantibacillus plantarum SR37-3 and SR61-2 in L-NAME-induced hypertensive rats[J]. Foods, 2022, 11(15): 2332.
[20] Chen Y,et al.Effect of combination treatment with metformin and probiotics Probio-Fit?on clinical symptoms and gut microbiota structure in type 2 diabetes[J].Journal of Chinese Institute of Food Science and Technology,2019,19(04):16-26.
[21] 呂孝國,李佃場,李雪敏,等.植物乳桿菌P-8在家禽生產中的應用研究進展[J].中國家禽,2020,42(12):96-100.
[22] An K, Gao W, Li P, et al. Dietary Lactobacillus plantarum improves the growth performance and intestinal health of Pekin ducks[J]. Poultry Science, 2022, 101(6): 101844.
[23] Chingwaru W, Vidmar J. Potential of Zimbabwean commercial probiotic products and strains of Lactobacillus plantarum as prophylaxis and therapy against diarrhoea caused by Escherichia coli in children [J]. Asian Pacific Journal of Tropical Medicine, 2017, 10(1): 57-63.
[24] Liu Y, Yu X, Yu L, et al. Lactobacillus plantarum CCFM8610 alleviates irritable bowel syndrome and prevents gut microbiota dysbiosis: A randomized, double-blind, placebo-controlled, pilot clinical trial [J]. Engineering, 2021, 7(3): 376-385.
[25] 劉超楠,蔡熙姮,張新宇,等.植物乳桿菌基因組學研究進展[J].食品科技,2020,45(11):1-7.


